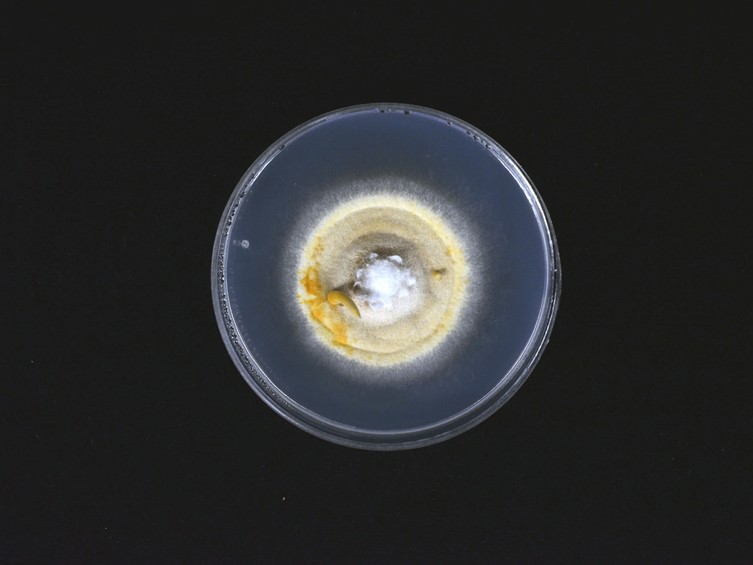

Holotype:
THAILAND, Phitsanulok Province, Ban Phaothai community forest, 10 Oct. 2015, A. Khonsanit, D. Thanakitpipattana, S. Lamlertthon, W. Noisripoom, S. Mongkolsamrit, holotype BBH 41710, extype living culture BCC 79272.
Habitat:
In leaf litter.
Host:
Seed (Smilacaceae)
Description:
 Stromata solitary or multiple, unbranched, tough, 20-75 mm long, 0.5-2 mm broad, cylindrical to enlarging apically, arising from the seed buried approximately 5-10 mm underground. Fertile part moderate orange yellow to brown orange, cylindrical to clavate, 5-20 mm long, 1.5-2.5 mm broad.
Stromata solitary or multiple, unbranched, tough, 20-75 mm long, 0.5-2 mm broad, cylindrical to enlarging apically, arising from the seed buried approximately 5-10 mm underground. Fertile part moderate orange yellow to brown orange, cylindrical to clavate, 5-20 mm long, 1.5-2.5 mm broad.  Perithecia completely immersed, ordinal in arrangement, narrow flask-shaped, 320-570 × 120-180 μm, ostioles darker reddish orange.
Perithecia completely immersed, ordinal in arrangement, narrow flask-shaped, 320-570 × 120-180 μm, ostioles darker reddish orange.  Asci cylindrical, 8-spored, 105-245 × 7-10 μm with caps 4-5 μm thick.
Asci cylindrical, 8-spored, 105-245 × 7-10 μm with caps 4-5 μm thick.  Ascospores hyaline, whole, filiform, 7-8 septate, 70-105 × 2-4 μm. Colour change of stromata in 3 % KOH not observed.
Ascospores hyaline, whole, filiform, 7-8 septate, 70-105 × 2-4 μm. Colour change of stromata in 3 % KOH not observed.
Culture characteristics:
Colony on PDA attaining 30–35 mm diam in 30 d, cottony with high mycelial density, pale yellow to strong orange yellow, reverse pale brown. Synnemata deep orange yellow, 5–20 × 2–2.5 mm. Conidiogenous structures consisting of erect conidiophores arising from the vegetative hyphae. Conidiophores consist of verticillate phialides, singly or in whorls of two. Phialides awl-shaped, 20–40 × 1.5–2.5 μm. Conidia hyaline, globose, not in chains, 4–6 μm diam. Chlamydospores not observed.
Colony on PDA attaining 30–35 mm diam in 30 d, cottony with high mycelial density, pale yellow to strong orange yellow, reverse pale brown. Synnemata deep orange yellow, 5–20 × 2–2.5 mm. Conidiogenous structures consisting of erect conidiophores arising from the vegetative hyphae. Conidiophores consist of verticillate phialides, singly or in whorls of two. Phialides awl-shaped, 20–40 × 1.5–2.5 μm. Conidia hyaline, globose, not in chains, 4–6 μm diam. Chlamydospores not observed.
Reference:
Mongkolsamrit S, Noisripoom W, Thanakitpipattana D, et al. (2021). New species in Aciculosporium, Shimizuomyces and a new genus Morakotia associated with plants in Clavicipitaceae from Thailand. Fungal systematics and evolution 8: 27–37.
DOI: https://doi.org/10.3114/fuse.2021.08.03Species |
Strain |
Compound |
Pubchem CID |
Biological activity |
Reference |
|---|
|
Strain |
LSU | RPB1 | RPB2 | TEF1 |
|---|---|---|---|---|
| BCC 64125 | KY794862 | - | KY794857 | KY794857 |
| BCC 79272 | KY794861 | KY794865 | KY794856 | KY794856 |
| BCC 79273 | KY794860 | KY794866 | - | - |